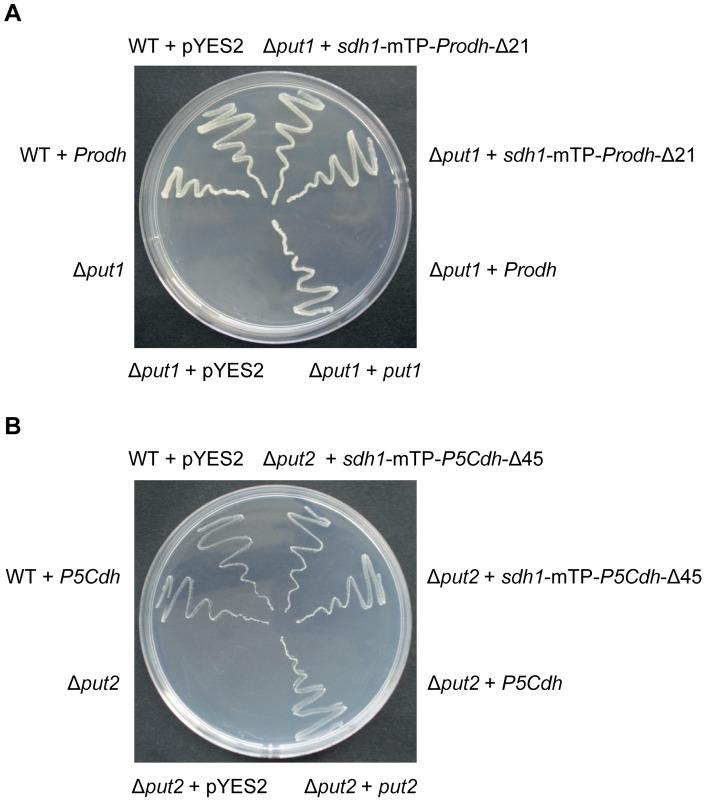
https://cdn.ncbi.nlm.nih.gov/pmc/blobs/a1d6/3767830/b1c6a7ef2753/pone.0073483.g003.jpg

Δ(1)-吡咯啉-5-羧酸/谷氨酸生物合成对于真菌的毒力和孢子形成是必需的。
Δ(1)-pyrroline-5-carboxylate/glutamate biogenesis is required for fungal virulence and sporulation.
机构信息
State Key Laboratory for Conservation and Utilization of Subtropical Agro-Bioresources, Key Laboratory of Ministry of Education for Microbial and Plant Genetic Engineering, College of Life Science and Technology, Guangxi University, Nanning, China.
出版信息
PLoS One. 2013 Sep 9;8(9):e73483. doi: 10.1371/journal.pone.0073483. eCollection 2013.
Proline dehydrogenase (Prodh) and Δ(1)-pyrroline-5-carboxylate dehydrogenase (P5Cdh) are two key enzymes in the cellular biogenesis of glutamate. Recombinant Prodh and P5Cdh proteins of the chestnut blight fungus Cryphonectria parasitica were investigated and showed activity in in vitro assays. Additionally, the C. parasitica Prodh and P5Cdh genes were able to complement the Saccharomyces cerevisiae put1 and put2 null mutants, respectively, to allow these proline auxotrophic yeast mutants to grow on media with proline as the sole source of nitrogen. Deletion of the Prodh gene in C. parasitica resulted in hypovirulence and a lower level of sporulation, whereas deletion of P5Cdh resulted in hypovirulence though no effect on sporulation; both Δprodh and Δp5cdh mutants were unable to grow on minimal medium with proline as the sole nitrogen source. In a wild-type strain, the intracellular level of proline and the activity of Prodh and P5Cdh increased after supplementation of exogenous proline, though the intracellular Δ(1)-pyrroline-5-carboxylate (P5C) content remained unchanged. Prodh and P5Cdh were both transcriptionally down-regulated in cells infected with hypovirus. The disruption of other genes with products involved in the conversion of arginine to ornithine, ornithine and glutamate to P5C, and P5C to proline in the cytosol did not appear to affect virulence; however, asexual sporulation was reduced in the Δpro1 and Δpro2 mutants. Taken together, our results showed that Prodh, P5Cdh and related mitochondrial functions are essential for virulence and that proline/glutamate pathway components may represent down-stream targets of hypovirus regulation in C. parasitica.
脯氨酸脱氢酶(Prodh)和 Δ(1)-吡咯啉-5-羧酸脱氢酶(P5Cdh)是谷氨酸细胞生物合成的两个关键酶。研究了栗疫病菌 Cryphonectria parasitica 的重组 Prodh 和 P5Cdh 蛋白,它们在体外测定中表现出活性。此外,栗疫病菌的 Prodh 和 P5Cdh 基因能够分别补充酿酒酵母的 put1 和 put2 缺失突变体,使这些脯氨酸营养缺陷型酵母突变体能够在以脯氨酸为唯一氮源的培养基上生长。栗疫病菌中 Prodh 基因的缺失导致弱毒和孢子形成水平降低,而 P5Cdh 基因的缺失导致弱毒,但对孢子形成没有影响;Δprodh 和 Δp5cdh 突变体均无法在以脯氨酸为唯一氮源的最小培养基上生长。在野生型菌株中,细胞内脯氨酸水平和 Prodh 和 P5Cdh 的活性在补充外源性脯氨酸后增加,尽管细胞内 Δ(1)-吡咯啉-5-羧酸(P5C)含量保持不变。Prodh 和 P5Cdh 在感染弱毒后的细胞中均转录下调。其他基因的破坏,这些基因的产物参与将精氨酸转化为鸟氨酸、鸟氨酸和谷氨酸转化为 P5C 以及 P5C 转化为脯氨酸,在细胞质中似乎不会影响毒力;然而,无性孢子形成在Δpro1 和 Δpro2 突变体中减少。总之,我们的结果表明 Prodh、P5Cdh 和相关的线粒体功能对毒力至关重要,脯氨酸/谷氨酸途径成分可能是栗疫病菌中弱毒调节的下游靶标。